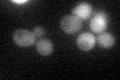
YJR096W
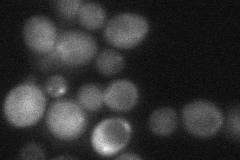
YJR096W
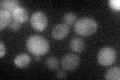
YJR096W

View description
Putative xylose and arabinose reductase; member of the aldo-keto reductase (AKR) family; GFP-fusion protein is induced in response to the DNA-damaging agent MMS
Localization:
Intensity:
Fold change:
Significance:
-
C’ GFP library in SD
cytosol28.47 -
N' NOP1pr-GFP in SD

cytosol207.782 -
N' TEF2pr-mCherry in SD

cytosol344.037 -
N' NATIVEpr-GFP in SD
cytosol,punctate33.2002 -
N' TEF2pr-VC and Cyto-VN in SD

cytosol67.7128 -
C’ GFP library in SD+DTT

cytosol46.051.61Yes -
C’ GFP library in SD+H2O2
cytosol35.541.24No -
C’ GFP library in Starvation Media

cytosol137.154.81Yes -
C’ GFP library on the background of Pup2-DaMP

cytosol -
C’ GFP library on the background of CCT mutant

cytosol26.04230.914439No
